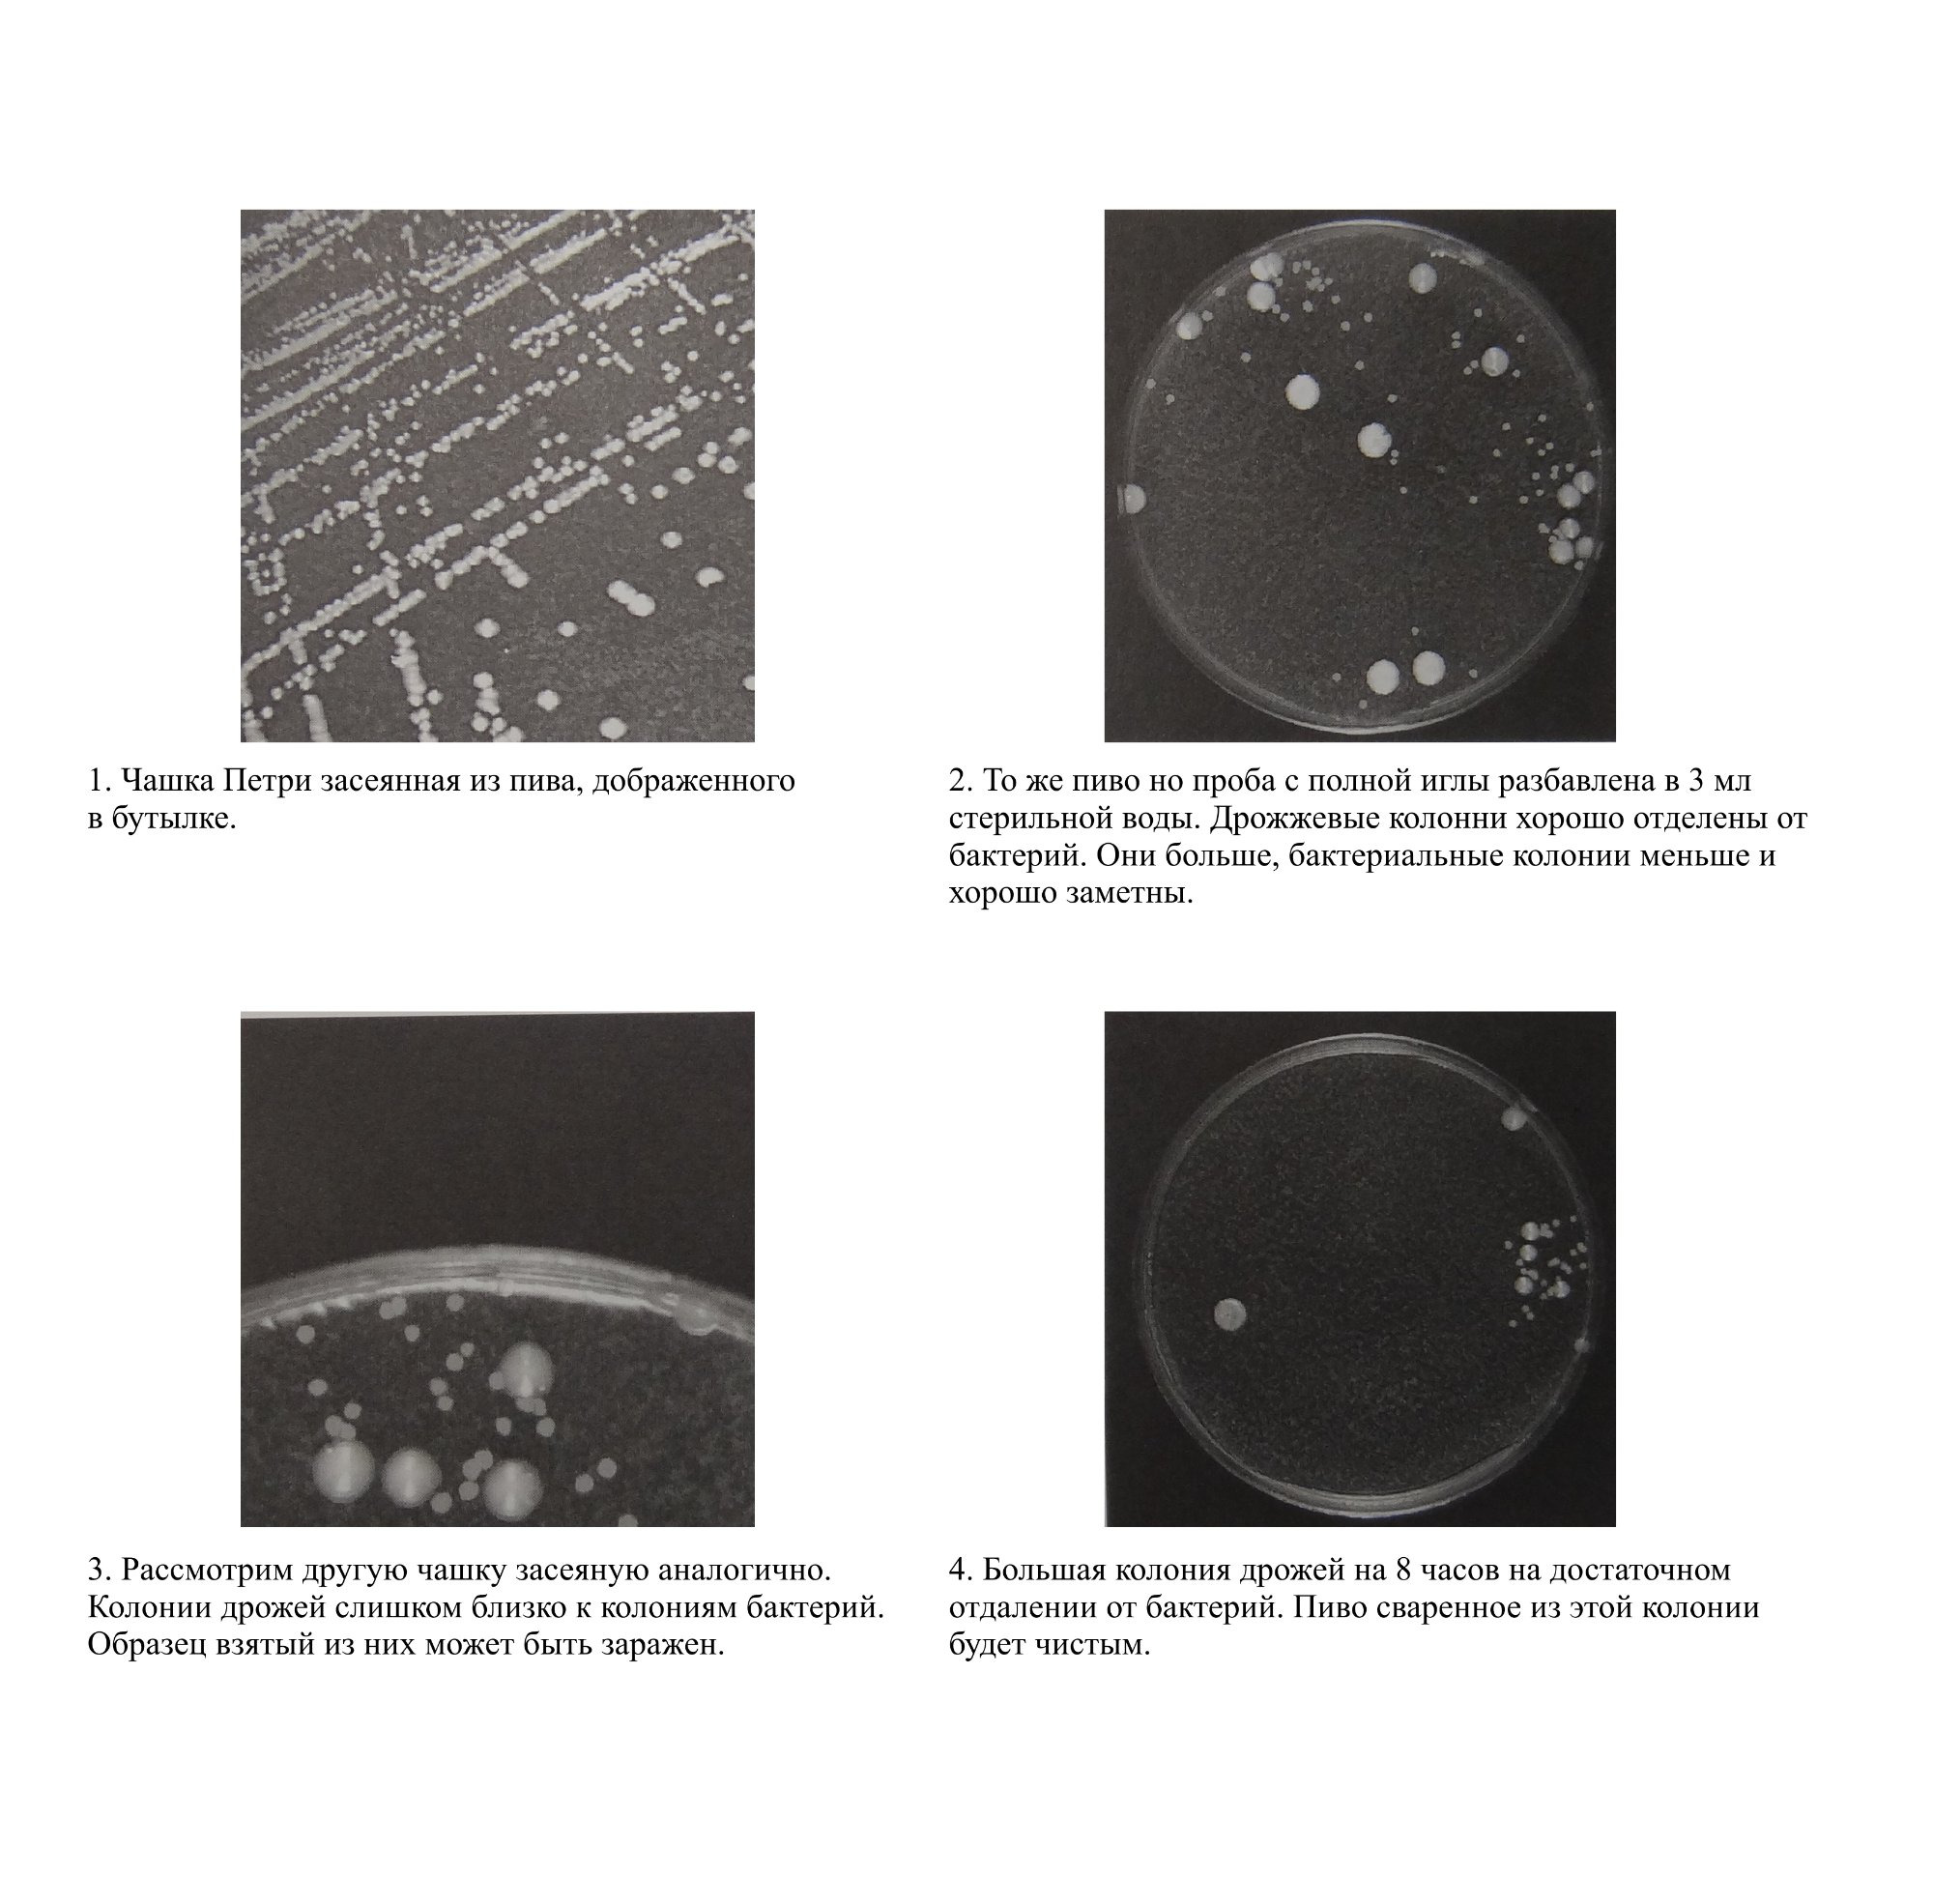

Бактерии
RomanBrewПри засевании чашек так же можно провести тест на наличие аэробных бактерий. Вид бактерий, которые могут расти на агаре из охмеленного сусла. Но на такой среде их можно обнаружить только при сильной концентрации. Если бактерий немного, то они заметны только на средах препятствующих росту дрожжей.
Бактерии патогенные для качества пива такие как молочнокислые бактерии и педиококи так же нуждаются в особой среде для роста и должны культивироваться в среде СО2. Они видны только на средах останавливающих рост дрожжей.